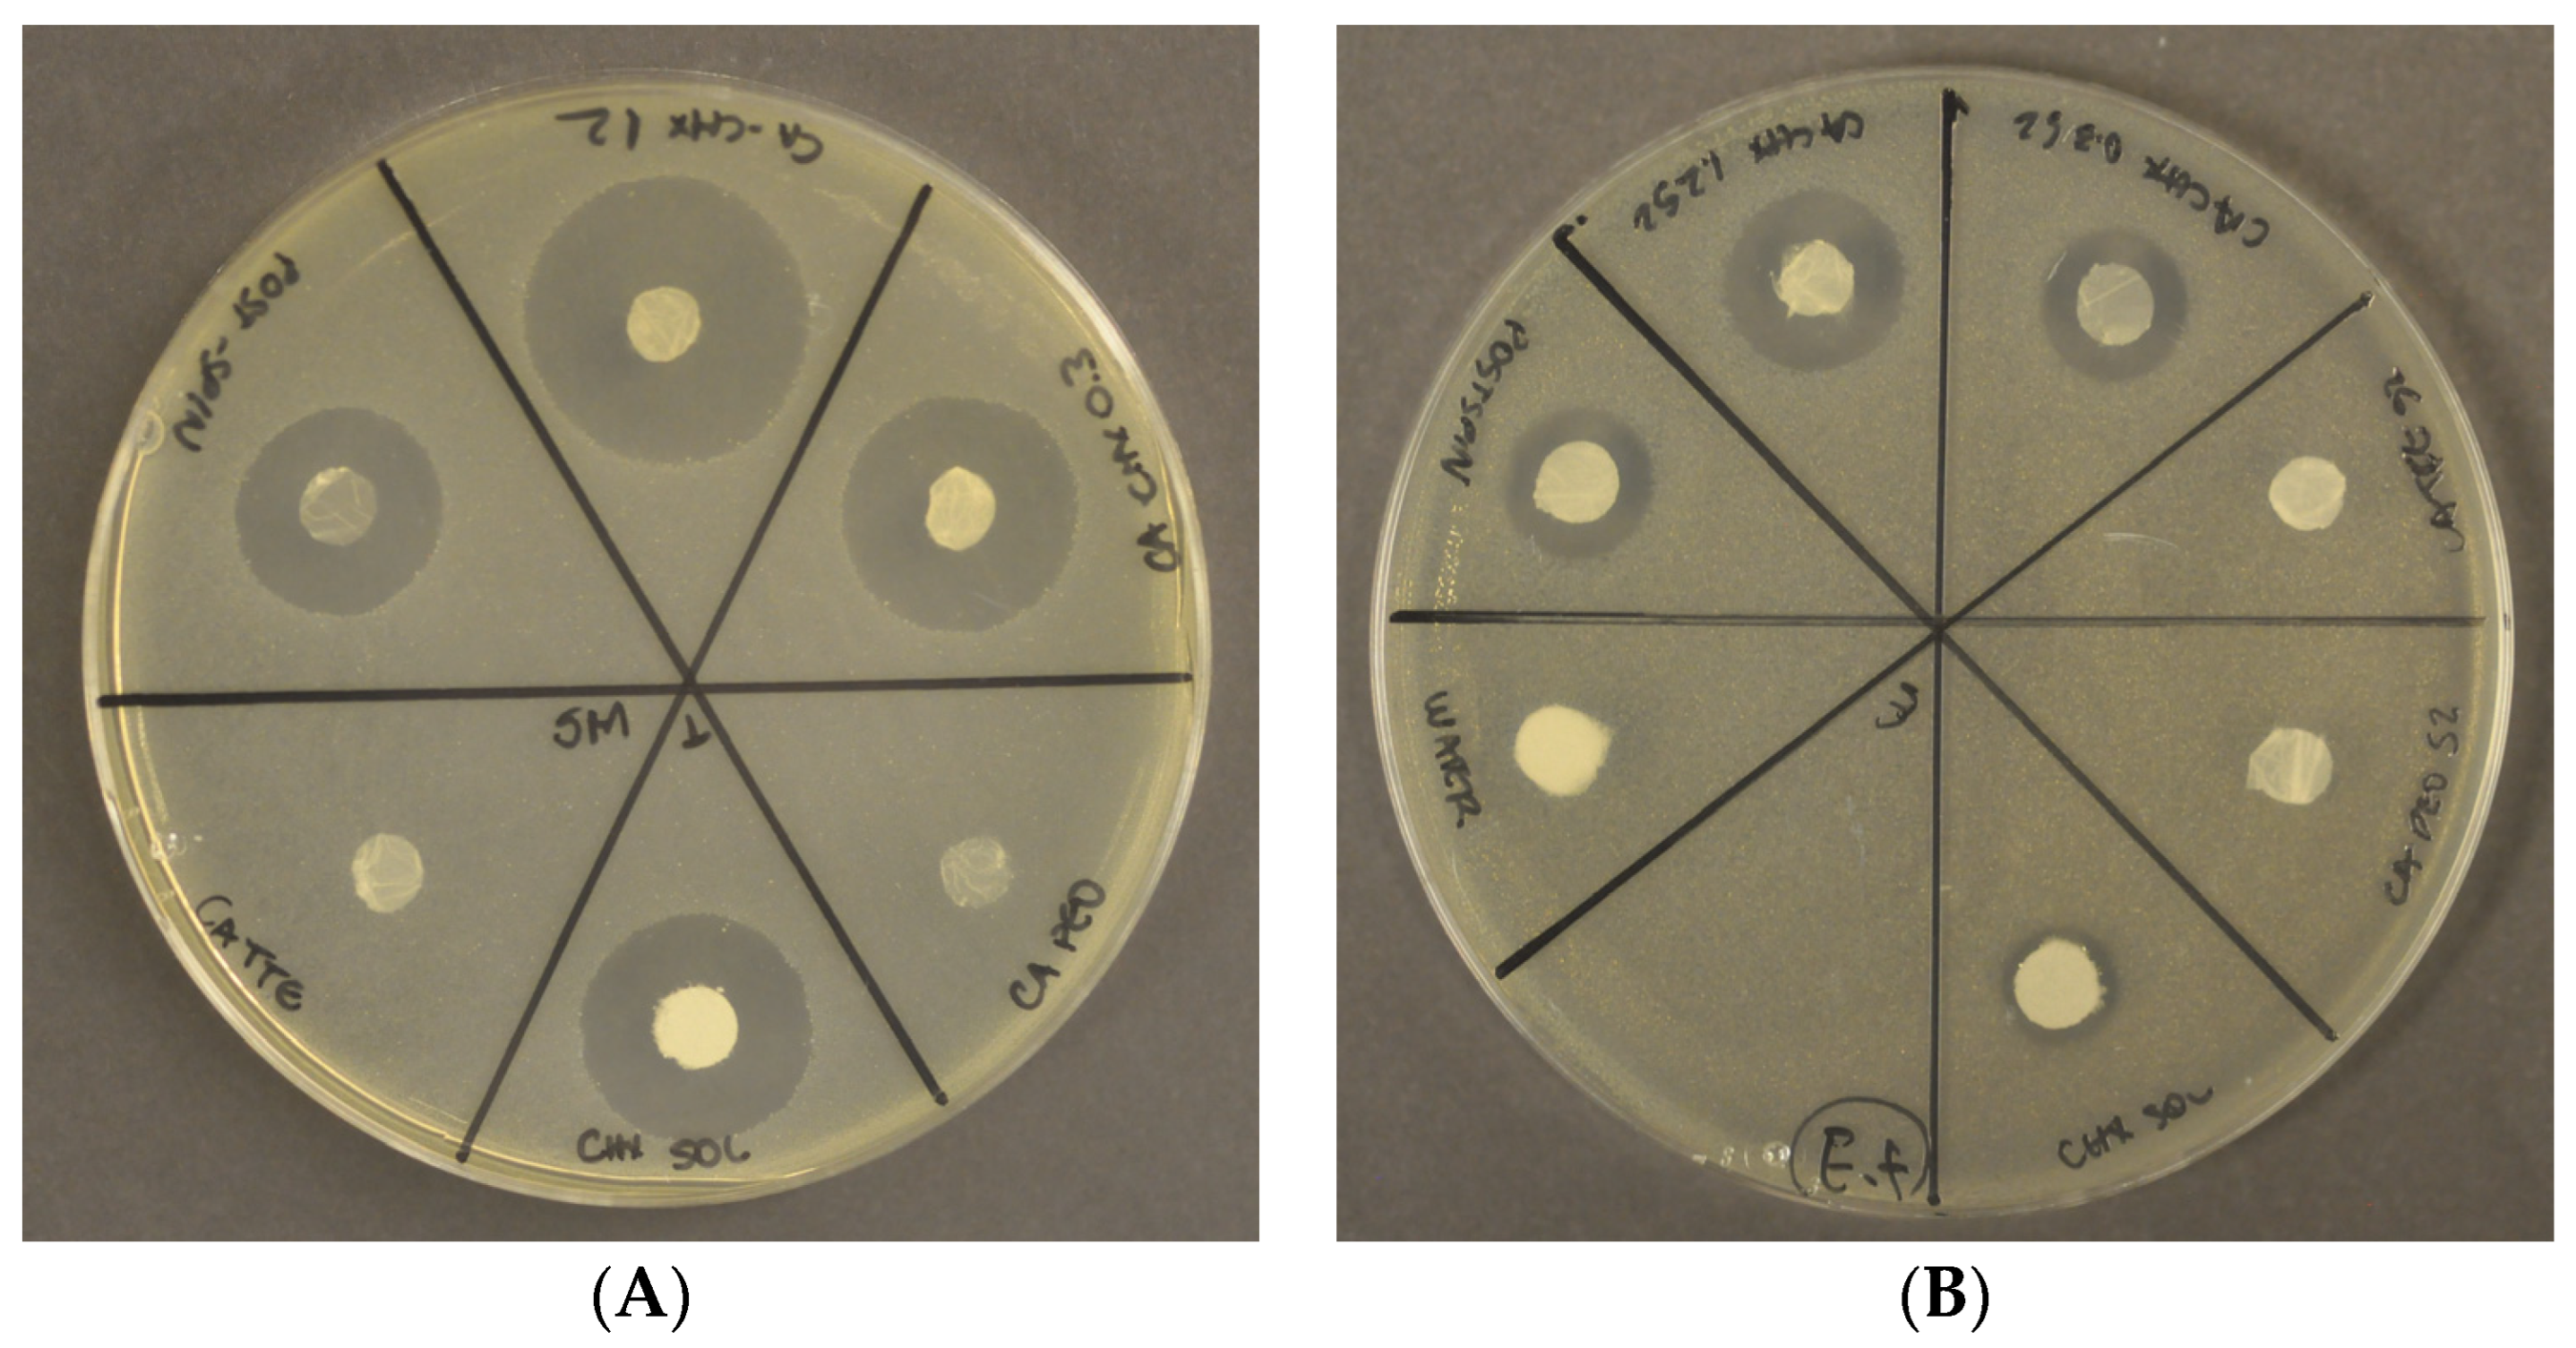

Chlorhexidine-Containing Electrospun Polymeric Nanofibers for Dental Applications: An In Vitro Study
Abstract
:1. Introduction
2. Results
2.1. Morphological Characterization
2.2. Nanofiber Mat Water Absorption
2.3. Drug Release
2.4. Antibacterial Assay
2.5. Minimum Bactericidal Concentration
3. Discussion
4. Materials and Methods
4.1. Nanofiber Mat Production
4.2. Nanofiber Water Absorption Studies
4.3. Morphological Characterization of Nanofibers
4.4. Chlorhexidine Release Profile
4.5. Antibacterial Assay
4.6. Minimum Bactericidal Concentration
4.7. Statistical Analysis
5. Conclusions
Author Contributions
Funding
Institutional Review Board Statement
Informed Consent Statement
Data Availability Statement
Acknowledgments
Conflicts of Interest
References
- Leung, V.; Ko, F. Biomedical Applications of Nanofibers. Polym. Adv. Technol. 2011, 22, 350–365. [Google Scholar] [CrossRef]
- Petrik, S. Industrial Production Technology for Nanofibers. In Nanofibers—Production, Properties and Functional Applications; Lin, T., Ed.; InTech: Houston, TX, USA, 2011; ISBN 978-953-307-420-7. [Google Scholar]
- Lee, J.B.; Park, H.N.; Ko, W.-K.; Bae, M.S.; Heo, D.N.; Yang, D.H.; Kwon, I.K. Poly(L-Lactic Acid)/Hydroxyapatite Nanocylinders as Nanofibrous Structure for Bone Tissue Engineering Scaffolds. J. Biomed. Nanotechnol. 2013, 9, 424–429. [Google Scholar] [CrossRef] [PubMed]
- Albuquerque, M.T.P.; Valera, M.C.; Moreira, C.S.; Bresciani, E.; de Melo, R.M.; Bottino, M.C. Effects of Ciprofloxacin-Containing Scaffolds on Enterococcus Faecalis Biofilms. J. Endod. 2015, 41, 710–714. [Google Scholar] [CrossRef] [PubMed]
- Bottino, M.C.; Kamocki, K.; Yassen, G.H.; Platt, J.A.; Vail, M.M.; Ehrlich, Y.; Spolnik, K.J.; Gregory, R.L. Bioactive Nanofibrous Scaffolds for Regenerative Endodontics. J. Dent. Res. 2013, 92, 963–969. [Google Scholar] [CrossRef] [PubMed]
- Tonglairoum, P.; Ngawhirunpat, T.; Rojanarata, T.; Panomsuk, S.; Kaomongkolgit, R.; Opanasopit, P. Fabrication of Mucoadhesive Chitosan Coated Polyvinylpyrrolidone/Cyclodextrin/Clotrimazole Sandwich Patches for Oral Candidiasis. Carbohydr. Polym. 2015, 132, 173–179. [Google Scholar] [CrossRef]
- Sill, T.J.; von Recum, H.A. Electrospinning: Applications in Drug Delivery and Tissue Engineering. Biomaterials 2008, 29, 1989–2006. [Google Scholar] [CrossRef]
- Sousa, M.G.C.; Maximiano, M.R.; Costa, R.A.; Rezende, T.M.B.; Franco, O.L. Nanofibers as Drug-Delivery Systems for Infection Control in Dentistry. Expert Opin. Drug Deliv. 2020, 17, 919–930. [Google Scholar] [CrossRef]
- Ambrosio, Z.M.H.; Marim, D.O.A.; Neto, P.C.N.; Robles, V.M.V.; Rolim, B.A. Method and Nanofibres Produced by Electrospinning Containing Active Substances for Controlled Release Cosmetic Application; World Intellectual Property Organization/WIPO: Geneva, Switzerland, 2014. [Google Scholar]
- Brookes, Z.L.S.; Bescos, R.; Belfield, L.A.; Ali, K.; Roberts, A. Current Uses of Chlorhexidine for Management of Oral Disease: A Narrative Review. J. Dent. 2020, 103, 103497. [Google Scholar] [CrossRef]
- Brookes, Z.L.S.; Belfield, L.A.; Ashworth, A.; Casas-Agustench, P.; Raja, M.; Pollard, A.J.; Bescos, R. Effects of Chlorhexidine Mouthwash on the Oral Microbiome. J. Dent. 2021, 113, 103768. [Google Scholar] [CrossRef]
- Poppolo Deus, F.; Ouanounou, A. Chlorhexidine in Dentistry: Pharmacology, Uses, and Adverse Effects. Int. Dent. J. 2022, 72, 269–277. [Google Scholar] [CrossRef]
- do Amaral, G.C.L.S.; Hassan, M.A.; Sloniak, M.C.; Pannuti, C.M.; Romito, G.A.; Villar, C.C. Effects of Antimicrobial Mouthwashes on the Human Oral Microbiome: Systematic Review of Controlled Clinical Trials. Int. J. Dent. Hyg. 2023, 21, 128–140. [Google Scholar] [CrossRef] [PubMed]
- Varoni, E.; Tarce, M.; Lodi, G.; Carrassi, A. Chlorhexidine (CHX) in Dentistry: State of the Art. Minerva Stomatol. 2012, 61, 399–419. [Google Scholar] [PubMed]
- Breschi, L.; Mazzoni, A.; Nato, F.; Carrilho, M.; Visintini, E.; Tjäderhane, L.; Ruggeri, A.; Tay, F.R.; Dorigo, E.D.S.; Pashley, D.H. Chlorhexidine Stabilizes the Adhesive Interface: A 2-Year in Vitro Study. Dent. Mater. 2010, 26, 320–325. [Google Scholar] [CrossRef] [PubMed]
- Carrilho, M.R.O.; Carvalho, R.M.; de Goes, M.F.; di Hipólito, V.; Geraldeli, S.; Tay, F.R.; Pashley, D.H.; Tjäderhane, L. Chlorhexidine Preserves Dentin Bond in Vitro. J. Dent. Res. 2007, 86, 90–94. [Google Scholar] [CrossRef]
- Ricci, H.A.; Sanabe, M.E.; de Souza Costa, C.A.; Pashley, D.H.; Hebling, J. Chlorhexidine Increases the Longevity of in Vivo Resin-Dentin Bonds. Eur. J. Oral Sci. 2010, 118, 411–416. [Google Scholar] [CrossRef]
- Carvalho, R.M.; Manso, A.P.; Geraldeli, S.; Tay, F.R.; Pashley, D.H. Durability of Bonds and Clinical Success of Adhesive Restorations. Dent. Mater. 2012, 28, 72–86. [Google Scholar] [CrossRef]
- Hebling, J.; Pashley, D.H.; Tjäderhane, L.; Tay, F.R. Chlorhexidine Arrests Subclinical Degradation of Dentin Hybrid Layers in Vivo. J. Dent. Res. 2005, 84, 741–746. [Google Scholar] [CrossRef]
- Carrilho, M.R.; Carvalho, R.M.; Sousa, E.N.; Nicolau, J.; Breschi, L.; Mazzoni, A.; Tjäderhane, L.; Tay, F.R.; Agee, K.; Pashley, D.H. Substantivity of Chlorhexidine to Human Dentin. Dent. Mater. 2010, 26, 779–785. [Google Scholar] [CrossRef]
- Ohkawa, K. Nanofibers of Cellulose and Its Derivatives Fabricated Using Direct Electrospinning. Molecules 2015, 20, 9139–9154. [Google Scholar] [CrossRef]
- Christoforou, T.; Doumanidis, C. Biodegradable Cellulose Acetate Nanofiber Fabrication via Electrospinning. J. Nanosci. Nanotechnol. 2010, 10, 6226–6233. [Google Scholar] [CrossRef]
- Khoshnevisan, K.; Maleki, H.; Samadian, H.; Shahsavari, S.; Sarrafzadeh, M.H.; Larijani, B.; Dorkoosh, F.A.; Haghpanah, V.; Khorramizadeh, M.R. Cellulose Acetate Electrospun Nanofibers for Drug Delivery Systems: Applications and Recent Advances. Carbohydr. Polym. 2018, 198, 131–141. [Google Scholar] [CrossRef] [PubMed]
- Castillo-Ortega, M.M.; Montaño-Figueroa, A.G.; Rodríguez-Félix, D.E.; Munive, G.T.; Herrera-Franco, P.J. Amoxicillin Embedded in Cellulose Acetate-Poly (Vinyl Pyrrolidone) Fibers Prepared by Coaxial Electrospinning: Preparation and Characterization. Mater. Lett. 2012, 76, 250–254. [Google Scholar] [CrossRef]
- Liu, X.; Lin, T.; Gao, Y.; Xu, Z.; Huang, C.; Yao, G.; Jiang, L.; Tang, Y.; Wang, X. Antimicrobial Electrospun Nanofibers of Cellulose Acetate and Polyester Urethane Composite for Wound Dressing. J. Biomed. Mater. Res. Part B Appl. Biomater. 2012, 100, 1556–1565. [Google Scholar] [CrossRef] [PubMed]
- Boyd, S.A.; Su, B.; Sandy, J.R.; Ireland, A.J. Cellulose Nanofibre Mesh for Use in Dental Materials. Coatings 2012, 2, 120–137. [Google Scholar] [CrossRef]
- Narang, R.S.; Narang, J.K. Nanomedicines for Dental Applications-Scope and Future Perspective. Int. J. Pharm. Investig. 2015, 5, 121. [Google Scholar] [CrossRef] [PubMed]
- Al-Harbi, N.; Hussein, M.A.; Al-Hadeethi, Y.; Felimban, R.I.; Tayeb, H.H.; Bedaiwi, N.M.H.; Alosaimi, A.M.; Bekyarova, E.; Chen, M. Bioactive Hybrid Membrane-Based Cellulose Acetate/Bioactive Glass/Hydroxyapatite/Carbon Nanotubes Nanocomposite for Dental Applications. J. Mech. Behav. Biomed. Mater. 2023, 141, 105795. [Google Scholar] [CrossRef] [PubMed]
- Samadian, H.; Zamiri, S.; Ehterami, A.; Farzamfar, S.; Vaez, A.; Khastar, H.; Alam, M.; Ai, A.; Derakhshankhah, H.; Allahyari, Z.; et al. Electrospun Cellulose Acetate/Gelatin Nanofibrous Wound Dressing Containing Berberine for Diabetic Foot Ulcer Healing: In Vitro and in Vivo Studies. Sci. Rep. 2020, 10, 8312. [Google Scholar] [CrossRef]
- Ahrari, F.; Eslami, N.; Rajabi, O.; Ghazvini, K.; Barati, S. The Antimicrobial Sensitivity of Streptococcus Mutans and Streptococcus Sangius to Colloidal Solutions of Different Nanoparticles Applied as Mouthwashes. Dent. Res. J. 2015, 12, 44–49. [Google Scholar]
- Sundararaj, S.C.; Al-Sabbagh, M.; Rabek, C.L.; Dziubla, T.D.; Thomas, M.V.; Puleo, D.A. Comparison of Sequential Drug Release in Vitro and in Vivo. J. Biomed. Mater. Res. Part B Appl. Biomater. 2016, 104, 1302–1310. [Google Scholar] [CrossRef] [PubMed]
- Çetin, E.Ö.; Buduneli, N.; Atlıhan, E.; Kırılmaz, L. In Vitro Studies on Controlled-Release Cellulose Acetate Films for Local Delivery of Chlorhexidine, Indomethacin, and Meloxicam. J. Clin. Periodontol. 2004, 31, 1117–1121. [Google Scholar] [CrossRef] [PubMed]
- Gao, Y.; Bach Truong, Y.; Zhu, Y.; Louis Kyratzis, I. Electrospun Antibacterial Nanofibers: Production, Activity, and in Vivo Applications. J. Appl. Polym. Sci. 2014, 131, 40797. [Google Scholar] [CrossRef]
- Sun, Y.; Cheng, S.; Lu, W.; Wang, Y.; Zhang, P.; Yao, Q. Electrospun Fibers and Their Application in Drug Controlled Release, Biological Dressings, Tissue Repair, and Enzyme Immobilization. RSC Adv. 2019, 9, 25712–25729. [Google Scholar] [CrossRef] [PubMed]
- Chen, L.; Bromberg, L.; Hatton, T.A.; Rutledge, G.C. Electrospun Cellulose Acetate Fibers Containing Chlorhexidine as a Bactericide. Polymer 2008, 49, 1266–1275. [Google Scholar] [CrossRef]
- Chou, S.-F.; Carson, D.; Woodrow, K.A. Current Strategies for Sustaining Drug Release from Electrospun Nanofibers. J. Control. Release 2015, 220, 584–591. [Google Scholar] [CrossRef] [PubMed]
- Deng, D.M.; Hoogenkamp, M.A.; Exterkate, R.A.M.; Jiang, L.M.; van der Sluis, L.W.M.; ten Cate, J.M.; Crielaard, W. Influence of Streptococcus Mutans on Enterococcus Faecalis Biofilm Formation. J. Endod. 2009, 35, 1249–1252. [Google Scholar] [CrossRef]
- Gonzales, J.R.; Harnack, L.; Schmitt-Corsitto, G.; Boedeker, R.H.; Chakraborty, T.; Domann, E.; Meyle, J. A Novel Approach to the Use of Subgingival Controlled-Release Chlorhexidine Delivery in Chronic Periodontitis: A Randomized Clinical Trial. J. Periodontol. 2011, 82, 1131–1139. [Google Scholar] [CrossRef]
- Priyadarshini, B.M.; Selvan, S.T.; Lu, T.B.; Xie, H.; Neo, J.; Fawzy, A.S. Chlorhexidine Nanocapsule Drug Delivery Approach to the Resin-Dentin Interface. J. Dent. Res. 2016, 95, 1065–1072. [Google Scholar] [CrossRef]
- Shen, C.; Zhang, N.-Z.; Anusavice, K.J. Fluoride and Chlorhexidine Release from Filled Resins. J. Dent. Res. 2010, 89, 1002–1006. [Google Scholar] [CrossRef]
- Stanislawczuk, R.; Reis, A.; Malaquias, P.; Pereira, F.; Farago, P.V.; Meier, M.M.; Loguercio, A.D. Mechanical Properties and Modeling of Drug Release from Chlorhexidine-Containing Etch-and-Rinse Adhesives. Dent. Mater. 2014, 30, 392–399. [Google Scholar] [CrossRef]
- Kwon, T.-Y.; Hong, S.-H.; Kim, Y.K.; Kim, K.-H. Antibacterial Effects of 4-META/MMA-TBB Resin Containing Chlorhexidine. J. Biomed. Mater. Res. Part B Appl. Biomater. 2010, 92, 561–567. [Google Scholar] [CrossRef]
- Seneviratne, C.J.; Leung, K.C.-F.; Wong, C.-H.; Lee, S.-F.; Li, X.; Leung, P.C.; Lau, C.B.S.; Wat, E.; Jin, L. Nanoparticle-Encapsulated Chlorhexidine against Oral Bacterial Biofilms. PLoS ONE 2014, 9, e103234. [Google Scholar] [CrossRef] [PubMed]
- Luo, D.; Zhang, X.; Shahid, S.; Cattell, M.J.; Gould, D.J.; Sukhorukov, G.B. Electrospun Poly(Lactic Acid) Fibers Containing Novel Chlorhexidine Particles with Sustained Antibacterial Activity. Biomater. Sci. 2016, 5, 111–119. [Google Scholar] [CrossRef] [PubMed]
- Arnold, R.R.; Wei, H.H.; Simmons, E.; Tallury, P.; Barrow, D.A.; Kalachandra, S. Antimicrobial Activity and Local Release Characteristics of Chlorhexidine Diacetate Loaded within the Dental Copolymer Matrix, Ethylene Vinyl Acetate. J. Biomed. Mater. Res. Part B Appl. Biomater. 2008, 86, 506–513. [Google Scholar] [CrossRef] [PubMed]

| CA-PEO | CA-TTE | CA-CHX 0.3 | CA-CHX 1.2 | CA-PEO POST-SPIN |
|---|---|---|---|---|
| 588 (±57) | 600 (±54) | 569 (±76) | 613 (±122) | 584 (±62) |
| Composition | |||||
|---|---|---|---|---|---|
| Groups | CA | PEO | TTE | DMF | CHX |
| CA-PEO | 0.78 g | 0.025 g | - | 12 g | - |
| CA-PEO-TTE | 0.78 g | 0.025 g | 0.12 g | 12 g | - |
| CA-PEO-TTE-CHX 0.3 | 0.78 g | 0.025 g | 0.12 g | 12 g | 0.038 g |
| CA-PEO-TTE-CHX 1.2 | 0.78 g | 0.026 g | 0.13 g | 12 g | 0.15 g |
| CA-PEO-POST-SPIN | 0.78 g | 0.025 g | - | 12 g | Post-spin treatment |
Disclaimer/Publisher’s Note: The statements, opinions and data contained in all publications are solely those of the individual author(s) and contributor(s) and not of MDPI and/or the editor(s). MDPI and/or the editor(s) disclaim responsibility for any injury to people or property resulting from any ideas, methods, instructions or products referred to in the content. |
© 2023 by the authors. Licensee MDPI, Basel, Switzerland. This article is an open access article distributed under the terms and conditions of the Creative Commons Attribution (CC BY) license (https://creativecommons.org/licenses/by/4.0/).
Share and Cite
de Carvalho, L.D.; Peres, B.U.; Shen, Y.; Haapasalo, M.; Maezono, H.; Manso, A.P.; Ko, F.; Jackson, J.; Carvalho, R.M. Chlorhexidine-Containing Electrospun Polymeric Nanofibers for Dental Applications: An In Vitro Study. Antibiotics 2023, 12, 1414. https://doi.org/10.3390/antibiotics12091414
de Carvalho LD, Peres BU, Shen Y, Haapasalo M, Maezono H, Manso AP, Ko F, Jackson J, Carvalho RM. Chlorhexidine-Containing Electrospun Polymeric Nanofibers for Dental Applications: An In Vitro Study. Antibiotics. 2023; 12(9):1414. https://doi.org/10.3390/antibiotics12091414
Chicago/Turabian Stylede Carvalho, Luana Dutra, Bernardo Urbanetto Peres, Ya Shen, Markus Haapasalo, Hazuki Maezono, Adriana P. Manso, Frank Ko, John Jackson, and Ricardo M. Carvalho. 2023. "Chlorhexidine-Containing Electrospun Polymeric Nanofibers for Dental Applications: An In Vitro Study" Antibiotics 12, no. 9: 1414. https://doi.org/10.3390/antibiotics12091414
APA Stylede Carvalho, L. D., Peres, B. U., Shen, Y., Haapasalo, M., Maezono, H., Manso, A. P., Ko, F., Jackson, J., & Carvalho, R. M. (2023). Chlorhexidine-Containing Electrospun Polymeric Nanofibers for Dental Applications: An In Vitro Study. Antibiotics, 12(9), 1414. https://doi.org/10.3390/antibiotics12091414






